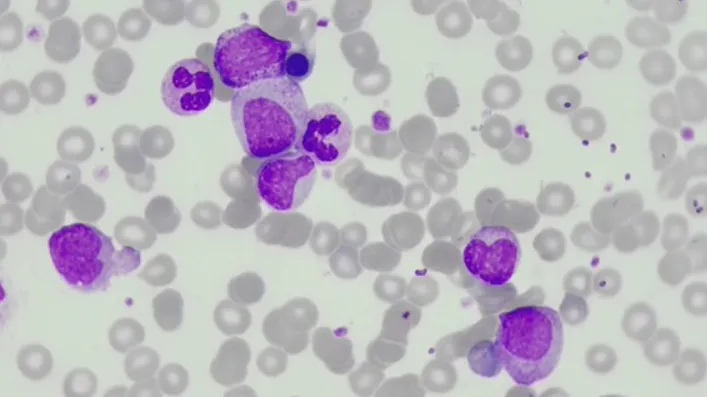

Leucemia Mieloide Crônica (LMC): Aspectos Hematológicos Essenciais
A Leucemia Mieloide Crônica (LMC) é uma neoplasia mieloproliferativa que se origina na medula óssea, caracterizada pela proliferação descontrolada de células mieloides maduras e em maturação.
Nesse sentido, sua marca distintiva é a presença do cromossomo Philadelphia (Ph). Para os analistas clínicos de laboratório, uma compreensão aprofundada dos aspectos moleculares e dos exames laboratoriais envolvidos é crucial para o diagnóstico e o monitoramento eficaz dos pacientes.
Imagem 1: Foto de um esfregaço sanguíneo de um paciente com leucemia mieloide crônica.
A Causa Molecular: O Gene de Fusão BCR-ABL1
A princípio, a LMC surge de uma translocação recíproca específica entre os cromossomos 9 e 22, t(9;22). Essa alteração genética resulta na formação do gene de fusão BCR-ABL1. Assim, este gene anômalo codifica uma proteína tirosina-quinase que permanece continuamente ativa.
Desse modo, essa atividade desregulada envia sinais constantes de proliferação celular, ignorando os mecanismos normais de controle de crescimento, o que leva ao acúmulo das células mieloides características da doença.
Fases da Leucemia Mieloide Crônica
A LMC progride tipicamente em duas fases distintas, cada uma com características clínicas e laboratoriais específicas:
- 1. Fase Crônica (FC)
- É a fase inicial da doença, geralmente com sintomas leves ou ausentes.
- Caracteriza-se por uma leucocitose acentuada com desvio à esquerda (aumento de mielócitos, metamielócitos e, ocasionalmente, promielócitos).
- A porcentagem de blastos no sangue periférico e na medula óssea é menor que 10%.
- Os exames laboratoriais frequentemente revelam basofilia e eosinofilia, além de trombocitose (contagem elevada de plaquetas), embora plaquetas normais ou baixas sejam raras nesta fase.
- Os pacientes geralmente respondem muito bem ao tratamento, especialmente aos inibidores de tirosina-quinase (ITQs), com um bom prognóstico.
- 2. Crise Blástica (CB)
- Esta é a fase mais agressiva da LMC, que se assemelha a uma leucemia aguda.
- É definida pela presença de 20% ou mais de blastos no sangue periférico ou na medula óssea.
- Pode haver também proliferação extramedular de blastos, formando massas tumorais (sarcomas mieloides).
- Os sintomas são mais graves e incluem febre, infecções, hemorragias e dor óssea, refletindo a falência medular. O prognóstico nesta fase é significativamente pior.

Diagnóstico Laboratorial Essencial da Leucemia Mieloide Crônica
O diagnóstico da LMC é estabelecido por uma combinação cuidadosa de exames laboratoriais:
- Hemograma:
- Geralmente revela leucocitose marcada, frequentemente acima de 100.000/µL, com um desvio à esquerda pronunciado (aumento de mielócitos e metamielócitos).
- A presença de basofilia e eosinofilia é comum e um achado importante.
- A contagem de plaquetas pode estar elevada (trombocitose) ou normal na fase crônica.
- Morfologia da Medula Óssea:
- Mostra hipercelularidade com um claro predomínio da série mieloide.
- Confirma a presença de basofilia e eosinofilia aumentadas.
- Citogenética Convencional (Cariótipo):
- Permite a detecção do cromossomo Philadelphia (Ph) nas células da medula óssea, que é fundamental para o diagnóstico.
- Biologia Molecular (RT-qPCR, FISH):
- A detecção do gene de fusão BCR-ABL1 é o método mais sensível para confirmar o diagnóstico e, crucialmente, para monitorar a resposta ao tratamento. A análise molecular por RT-qPCR quantifica a carga de BCR-ABL1, sendo indispensável para acompanhar a eficácia terapêutica e a progressão da doença.
Conclusão
Portanto, a LMC é uma doença hematológica com uma base molecular bem caracterizada pelo gene BCR-ABL1. Assim, para os analistas clínicos de laboratório, um diagnóstico preciso e o monitoramento contínuo através de exames laboratoriais sensíveis e específicos são de extrema importância.
Por fim, a detecção precoce e o acompanhamento molecular rigoroso têm transformado o prognóstico dos pacientes com LMC, destacando o papel indispensável do laboratório na prática hematológica moderna.
O próximo passo de todo analista que deseja ter mais segurança na bancada
Todo analista que busca se destacar e se tornar um profissional mais atualizado, capacitado e qualificado para o mercado de trabalho precisa considerar uma pós-graduação.
Um profissional com especialização é valorizado na área laboratorial; esse é um fato inegável.
Unimos o útil ao agradável ao desenvolver uma pós-graduação em Hematologia Laboratorial e Clínica.
Para aqueles que procuram a comodidade de uma pós-graduação 100% online e ao vivo, sem abrir mão da excelência no ensino, temos a solução ideal.
Nossa metodologia combina teoria e prática da rotina laboratorial, garantindo um aprendizado efetivo.
Contamos com um corpo docente altamente qualificado, com os melhores professores do Brasil, referências em suas áreas de atuação.
No Instituto Nacional de Medicina Laboratorial, temos apenas um objetivo: mais do que ensinar, vamos tornar VOCÊ uma referência.
Toque no botão abaixo e conheça a pós-graduação em Hematologia Laboratorial e Clínica.
QUERO CONHECER TODOS OS DETALHES DA PÓS-GRADUAÇÃO
Referências:
Instituto Nacional de Câncer José Alencar Gomes da Silva (INCA). Leucemia.
Universidade Federal de São Paulo (UNIFESP). Fevereiro Laranja: Leucemia.
Sossela, F. R., & de Oliveira, B. C. (2017). Leucemia Mieloide Crônica: aspectos clínicos, diagnóstico e principais alterações observadas no hemograma. Revista Brasileira de Análises Clínicas, 49(2), 143–148.



